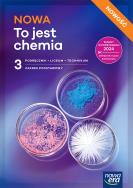
Okładka książki Nowa chemia podręcznik 3 liceum i technikum zakres podstawowy edycja 2026

Kategorie
|
|
Nowa Erasortuj:
tytuł
cena
data
tylko dostępne

Pakiet: Od ucha do ucha. Poziom 4
185,56 zł
219,00 zł
Najniższa cena z ostatnich 30 dni: 185,56 zł

Pakiet Hop! Do szkoły 6-latki
nowość
185,25 zł
219,00 zł
Najniższa cena z ostatnich 30 dni: 185,56 zł

Nowa Biologia na czasie 2 SMARTBOOK liceum i technikum zakres podstawowy EDYCJA 2026
52,89 zł
62,90 zł
Najniższa cena z ostatnich 30 dni: 51,27 zł
Nowa chemia podręcznik 3 liceum i technikum zakres podstawowy edycja 2026
52,56 zł
62,50 zł
Najniższa cena z ostatnich 30 dni: 51,27 zł

Matematyka LO 1 Nowa MATeMAtyka KP + zbiór ZPiR
32,42 zł
38,50 zł
Najniższa cena z ostatnich 30 dni: 31,57 zł

Matematyka LO 1 Nowa MATeMAtyka KP + zbiór ZP
30,69 zł
36,50 zł
Najniższa cena z ostatnich 30 dni: 29,89 zł

Matematyka Nowa Teraz Matura ZP cz.1 KP
36,08 zł
42,90 zł
Najniższa cena z ostatnich 30 dni: 35,23 zł

Nowa Geografia Oblicza geografii 2 SMARTBOOK liceum i technikum zakres podstawowy EDYCJA 2025
52,89 zł
62,90 zł
Najniższa cena z ostatnich 30 dni: 51,27 zł

Nowa Historia poznać przeszłość 2 SMARTBOOK liceum i technikum zakres podstawowy edycja 2025
52,89 zł
62,90 zł
Najniższa cena z ostatnich 30 dni: 51,27 zł

J. Niemiecki 3 Welttour Deutsch neu Podr
61,31 zł
72,90 zł
Najniższa cena z ostatnich 30 dni: 59,69 zł

Historia Poznać przeszłość 1 LO SmartB ZP 2025
52,89 zł
62,90 zł
Najniższa cena z ostatnich 30 dni: 51,27 zł

J.angielski PP NOWATERAZ MATURA ZPiR Vad 25/26
67,20 zł
79,90 zł
Najniższa cena z ostatnich 30 dni: 65,16 zł

Biologia PP NOWA na czasie 1 ZP Smartbook 2025
52,89 zł
62,90 zł
Najniższa cena z ostatnich 30 dni: 51,27 zł

Geografia NOWE Oblicza geogr 1 Smartbook ZP/25
52,89 zł
62,90 zł
Najniższa cena z ostatnich 30 dni: 51,27 zł

Matematyka PP NOWA TERAZ MATURA ZP Vadem 25/26
67,20 zł
79,90 zł
Najniższa cena z ostatnich 30 dni: 65,16 zł

Matematyka PP NOWA TERAZ MATURA ZR Vadem 25/26
67,20 zł
79,90 zł
Najniższa cena z ostatnich 30 dni: 65,16 zł

Matematyka PP NOWA TERAZ MATURA ZP ZZM 2025/26
42,81 zł
50,90 zł
Najniższa cena z ostatnich 30 dni: 41,67 zł

Matematyka PP NOWA TERAZ MATURA ZR ZZM 2025/26
42,81 zł
50,90 zł
Najniższa cena z ostatnich 30 dni: 41,67 zł

J.polski PP NOWA TERAZ MATURA ZP Vadem 2025/26
67,20 zł
79,90 zł
Najniższa cena z ostatnich 30 dni: 65,26 zł

J.polski PP NOWA TERAZ MATURA ZR Vadem 2025/26
67,20 zł
79,90 zł
Najniższa cena z ostatnich 30 dni: 65,16 zł
numer strony:
Liczba wyświetlanych pozycji:
Uwaga!!!
Ten produkt jest zapowiedzią. Realizacja Twojego zamówienia ulegnie przez to wydłużeniu do czasu premiery tej pozycji. Czy chcesz dodać ten produkt do koszyka?
TAK
NIE


Wybierz wariant produktu
|
||||||||||||||||||||||||||||||||||||||||||||||||||||||||||||||||||||||||||||||||